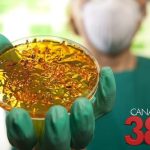

Apenas 22% do público-alvo se vacinou contra a gripe
População prioritária é de 75,8 milhões de pessoas Dados do Ministério da Saúde mostram que apenas 22% do público-alvo se vacinou contra a gripe. Até o momento, 14,4 milhões de

População prioritária é de 75,8 milhões de pessoas Dados do Ministério da Saúde mostram que apenas 22% do público-alvo se vacinou contra a gripe. Até o momento, 14,4 milhões de

Últimos casos autóctones ocorreram em Pernambuco em 2004 e 2005. ouvir: O Ministério da Saúde confirmou nesta sexta-feira (19) um caso autóctone de cólera em Salvador, o que significa que

Distrito Federal tem maior proporção de casos prováveis O Brasil alcançou a marca dos 1.601 óbitos por dengue confirmados em 2024. Além disso, outras duas mil mortes seguem em investigação

Saúde confirmou compra de 12,5 milhões de doses da Moderna O Ministério da Saúde confirmou a compra de 12,5 milhões de doses de vacina contra a covid-19 da farmacêutica Moderna.

Com aumento da tributação, instituto espera queda no consumo O Instituto Nacional do Câncer (Inca) divulgou nota em apoio ao aumento de impostos sobre as bebidas alcoólicas como uma das

Casos de covid-19 têm tendência de queda. ouvir: O Boletim InfoGripe, divulgado nesta semana pela Fundação Oswaldo Cruz (Fiocruz), chama atenção para alta das internações por Síndrome Respiratória Aguda Grave

Fabricação e comercialização são proibidas no país desde 2009 A diretoria colegiada da Agência Nacional de Vigilância Sanitária (Anvisa) discute nesta sexta-feira (19) a regulamentação de cigarros eletrônicos no Brasil.

O hospital atende os 115 municípios que fazem parte da macrorregião Noroeste. O HUM é habilitado desde 2014 para realizar dois procedimentos por mês – as primeiras começaram em 2016.

Doses atualizadas protegem contra variante XBB do vírus Novas doses da vacina contra covid-19 devem chegar na próxima semana para serem distribuídas aos estados, segundo o Ministério da Saúde. O

Proposta é reduzir a transmissão vertical do vírus durante amamentação O Ministério da Saúde ampliou o uso de testes para diagnóstico do vírus Linfotrópico de Células T Humanas (HTLV) na

População prioritária é de 75,8 milhões de pessoas Dados do Ministério da Saúde mostram que apenas 22% do público-alvo se vacinou contra a gripe. Até o momento, 14,4 milhões de
Últimos casos autóctones ocorreram em Pernambuco em 2004 e 2005. ouvir: O Ministério da Saúde confirmou nesta sexta-feira (19) um caso autóctone de cólera em Salvador, o que significa que

Distrito Federal tem maior proporção de casos prováveis O Brasil alcançou a marca dos 1.601 óbitos por dengue confirmados em 2024. Além disso, outras duas mil mortes seguem em investigação

Saúde confirmou compra de 12,5 milhões de doses da Moderna O Ministério da Saúde confirmou a compra de 12,5 milhões de doses de vacina contra a covid-19 da farmacêutica Moderna.

Com aumento da tributação, instituto espera queda no consumo O Instituto Nacional do Câncer (Inca) divulgou nota em apoio ao aumento de impostos sobre as bebidas alcoólicas como uma das

Casos de covid-19 têm tendência de queda. ouvir: O Boletim InfoGripe, divulgado nesta semana pela Fundação Oswaldo Cruz (Fiocruz), chama atenção para alta das internações por Síndrome Respiratória Aguda Grave

Fabricação e comercialização são proibidas no país desde 2009 A diretoria colegiada da Agência Nacional de Vigilância Sanitária (Anvisa) discute nesta sexta-feira (19) a regulamentação de cigarros eletrônicos no Brasil.

O hospital atende os 115 municípios que fazem parte da macrorregião Noroeste. O HUM é habilitado desde 2014 para realizar dois procedimentos por mês – as primeiras começaram em 2016.

Doses atualizadas protegem contra variante XBB do vírus Novas doses da vacina contra covid-19 devem chegar na próxima semana para serem distribuídas aos estados, segundo o Ministério da Saúde. O

Proposta é reduzir a transmissão vertical do vírus durante amamentação O Ministério da Saúde ampliou o uso de testes para diagnóstico do vírus Linfotrópico de Células T Humanas (HTLV) na